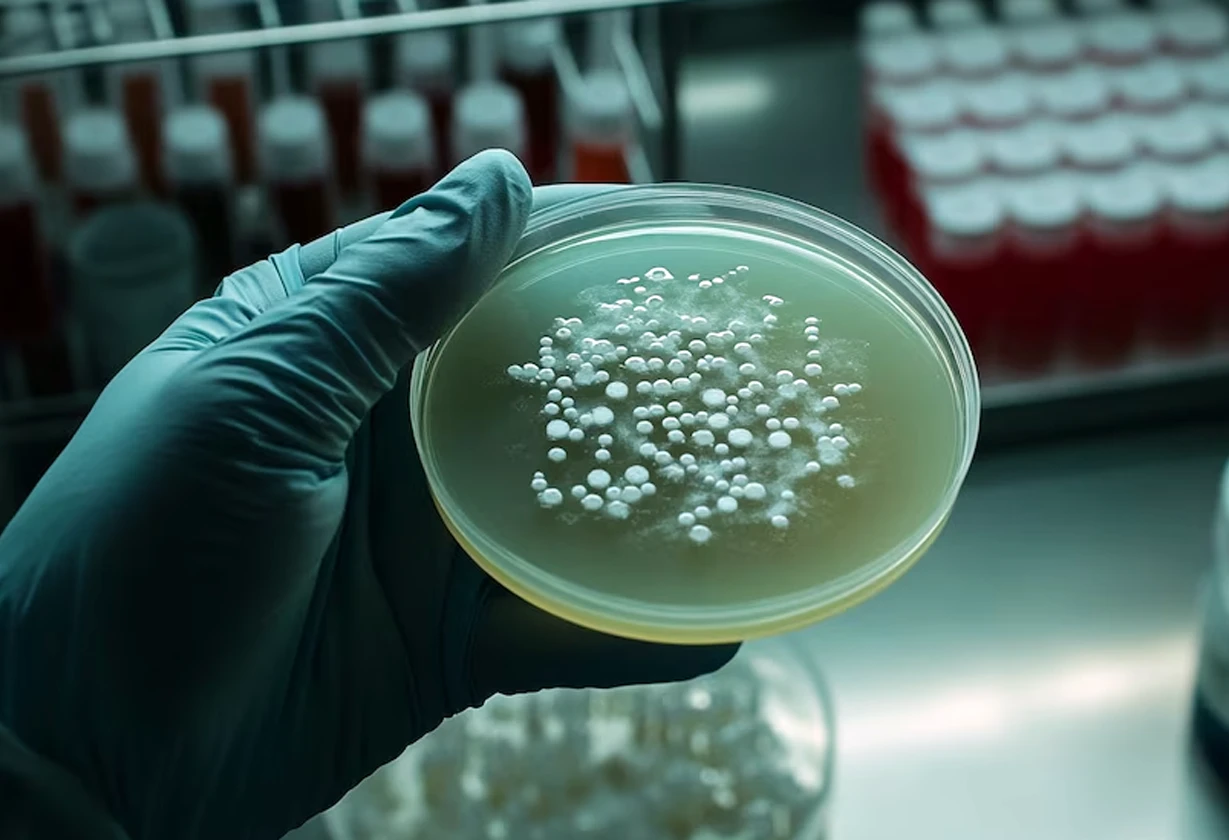

Descubren en Río Negro un lagarto fósil del Cretácico tardío y reconstruyen su anatomía con tecnología avanzada sin dañar los restos.

Descubren en Río Negro un lagarto fósil del Cretácico tardío y reconstruyen su anatomía con tecnología avanzada sin dañar los restos.

Software argentino basado en IA permite predecir agregación de proteínas asociadas a Alzheimer, Parkinson y ELA, con impacto en salud public

Registro histórico de una medusa fantasma gigante en el Mar Argentino durante una campaña del CONICET que exploró zonas profundas
Descubrimiento argentino combina cannabidiol y antibiótico para combatir bacterias resistentes y reducir efectos tóxicos en tratamientos hospitalarios

Nueva especie Yeneen houssayi, titanosaurio de 83 millones de años hallado en Neuquén. Detalles del fósil y su aporte al estudio de saurópodos

Avance científico argentino impulsa marcapasos con variabilidad cardíaca y redefine el rol del nodo sinusal en la regulación del corazón.

Investigadores argentinos detectaron restos de fármacos en ríos del Río de la Plata y alertan sobre efectos ambientales y sanitarios

Vacuna ARNm contra gripe aviar avanza en ensayos preclínicos en Argentina con apoyo internacional.

Expedición de la UBA y el CONICET explorará ecosistemas extremos del Mar Argentino con transmisiones en vivo y tecnología avanzada.

Científicos argentinos introducen AR2015, virus oncolítico que ataca células resistentes del cáncer colorrectal mediante A33 y vWA2, limitando metástasis hepáticas con seguridad y combinación quimioterapéutica.